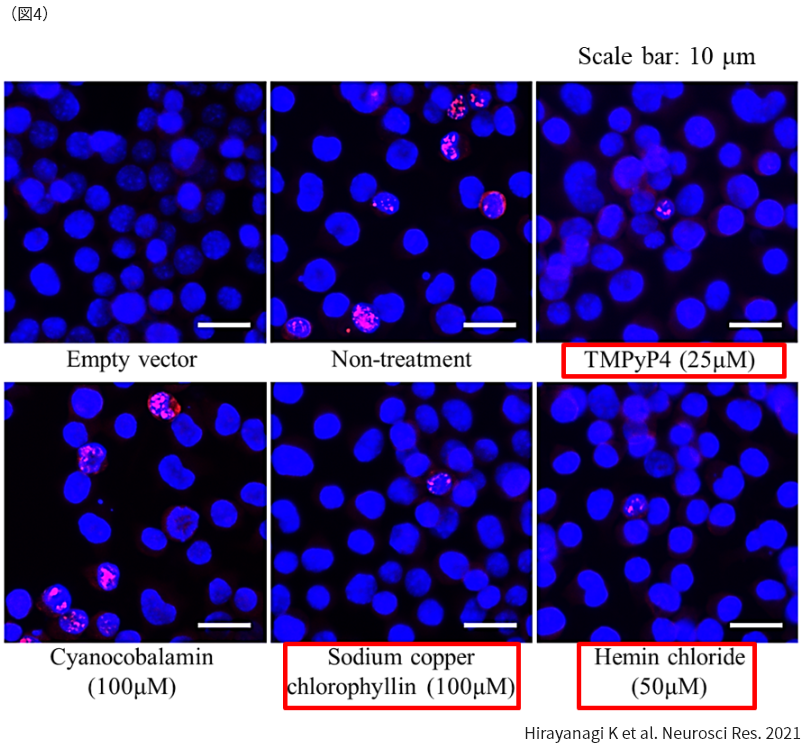

脊髄小脳変性症(spinocerebellar degeneration: SCD)とは
中枢神経系の中で、小脳を中心とした部位に神経細胞脱落を生じる原因不明の疾患です。臨床的には、起立時・歩行時のふらつき、手の使いづらさ、呂律が悪いといった症状が特徴で、これらは医学的に「小脳失調」と呼ばれます。現時点で根治的治療法は存在せず、「難病の患者に対する医療等に関する法律」に基づき、厚生労働省より指定難病の1つに指定されています。
脊髄小脳失調症(spinocerebellar ataxia: SCA)とは
脊髄小脳変性症は大きく、孤発性(非遺伝性)と遺伝性(家族性)に分類されます。脳神経内科で担当する神経変性疾患は色々とありますが、脊髄小脳変性症では遺伝性の患者さんが全体の約30%と多いのが特徴です。
遺伝性脊髄小脳変性症のうち、常染色体顕性(優性)遺伝形式で疾患が伝達されるタイプを脊髄小脳失調症(SCA)と呼びます。SCDと用語が似ていますが、SCAと言えば専ら、顕性(優性)遺伝性のタイプを総称する場合に用い、原因遺伝子が発見された順番に、SCA1、SCA2・・・というように番号が付けられます。
ヒトの身体を構成し様々な生命現象を司るタンパクの設計図ともいうべきものを遺伝子と呼びます。ヒトの遺伝子の数は約2万種類と考えられています。SCAではその中の特定の1つの遺伝子に変異(遺伝子を構成する塩基配列の違い)を生じることで疾患を発症します。
さまざまなSCAについて
2026年時点で、SCAの原因遺伝子は50種類以上あることが分かっています。SCA研究の歴史上、1993年、最初にSCA1の原因遺伝子がアタキシン1遺伝子のエクソン(タンパク翻訳領域)にあるCAGという塩基のくり返し配列の異常な伸長であることが発見されました。CAGはアタキシン1タンパクを翻訳する際にはグルタミンというアミノ酸の遺伝暗号となり、長いCAGくり返し配列は長いグルタミンの連なり(ポリグルタミンと呼びます)を生成する指令となります。
その後SCA1のみならず、SCA2、MJD/SCA3、SCA6やDRPLAといった病型も異なる遺伝子内におけるCAGくり返し配列伸長が原因遺伝子変異であることが判明し、遺伝性脊髄小脳変性症の分子病態研究が大きく発展することになりました。下の図1に示す如く、その後多くのSCAの原因遺伝子が発見されましたが、CAGくり返し配列伸長を原因とする病型のみならず、様々なタイプの遺伝子変異が原因となることが判明しています。

非翻訳リピート伸長病について
群馬大学脳神経内科では、このように遺伝学的にも大きな多様性のあるSCAのうち、非翻訳リピート伸長病をターゲットとして研究を推進しています。非翻訳リピート伸長病とは、遺伝子の構造上のイントロンまたは5’側、3’側UTRと呼ばれる非翻訳領域(タンパクの構成成分であるアミノ酸の遺伝暗号とならない部分)に存在する、3塩基から6塩基からなる様々な塩基配列モチーフの異常伸長を原因遺伝子変異とする疾患群のことをいいます。
先に述べたSCA1などのCAGくり返し配列伸長病(ポリグルミン病)に比べると、くり返しのある塩基配列モチーフに多様性があり、ポリグルタミン病の変異CAGくり返し数が概ね100リピート以内であるのに対して、非翻訳リピート伸長病における伸長くり返し数は5000リピート位まで高度に伸長する疾患もあることが知られています。
下の図2では、様々なくり返し塩基配列伸長を原因とする疾患を模式的に示しています。異なる塩基配列モチーフを遺伝子変異とする疾患をグループ分けして別々の色で示しています。また、伸長くり返し配列の背の高さは最大くり返し数を相対的に示しています。

SCA36の培養細胞モデル作成と治療開発研究
群馬大学脳神経内科では現在、図2にある疾患群のうち、NOP56遺伝子イントロン1に存在するGGCCTGという6塩基くり返し配列の伸長を原因遺伝子変異とするSCA36(脊髄小脳失調症36型)などについて、その遺伝子変異を人工的に培養細胞へ導入した疾患モデルの作成とそれを用いた治療開発研究を推進しています。

図3はSCA36病態研究の一部を示しています。写真の中の青く丸い構造物は培養神経細胞の核を示しており、核の中には伸長GGCTGリピートからRNAに転写された後に凝集して生じた、伸長GGCUGリピート凝集物(RNA fociと呼びます)が赤色で示されています。この所見はSCA36患者さんの剖検脳で確認されているのと同様であることより、SCA36の培養細胞モデルとなり得ることを示しています。
また、上記のSCA36培養細胞モデルを用いて、病態に特異的に作用する治療候補薬の開発を推進しています。下の図4はSCA36培養細胞モデルに対して、治療候補になり得ると想定した、ポルフィリン誘導体と呼ばれる複数の化合物を添加した場合の変化を示しています。何も化合物を添加しない場合(Non-treatment)に比べて、赤色の枠で囲った3種類の化合物を加えた場合では、GGCUGリピート凝集物(RNA foci、赤色)の形成が抑制されています。さらに別の解析によって、これらの化合物を添加することにより、GGCUGリピート凝集物の細胞毒性を減らし、細胞生存率を上げる結果が確認されました。よってこれらの化合物は、SCA36患者さんにおいてもRNA foci形成および神経細胞障害を抑制する可能性があり、さらなる検討を進めることにしています。
まとめ
臨床所見上も、また病態においても高度の多様性がある脊髄小脳変性症を克服するため、非翻訳リピート伸長病をターゲットとして病態解明と治療開発研究を推進しています。これらの研究を通じて、すべての脊髄小脳変性症患者さんの治療に応用できる発見を目指して邁進しています。また、上記の基礎的研究に加え、将来的な臨床試験への応用を目指して、小脳失調の重症度を定量的に評価する装置の開発についても、群馬大学理工学府の皆さんと研究グループを形成して推進しています。
